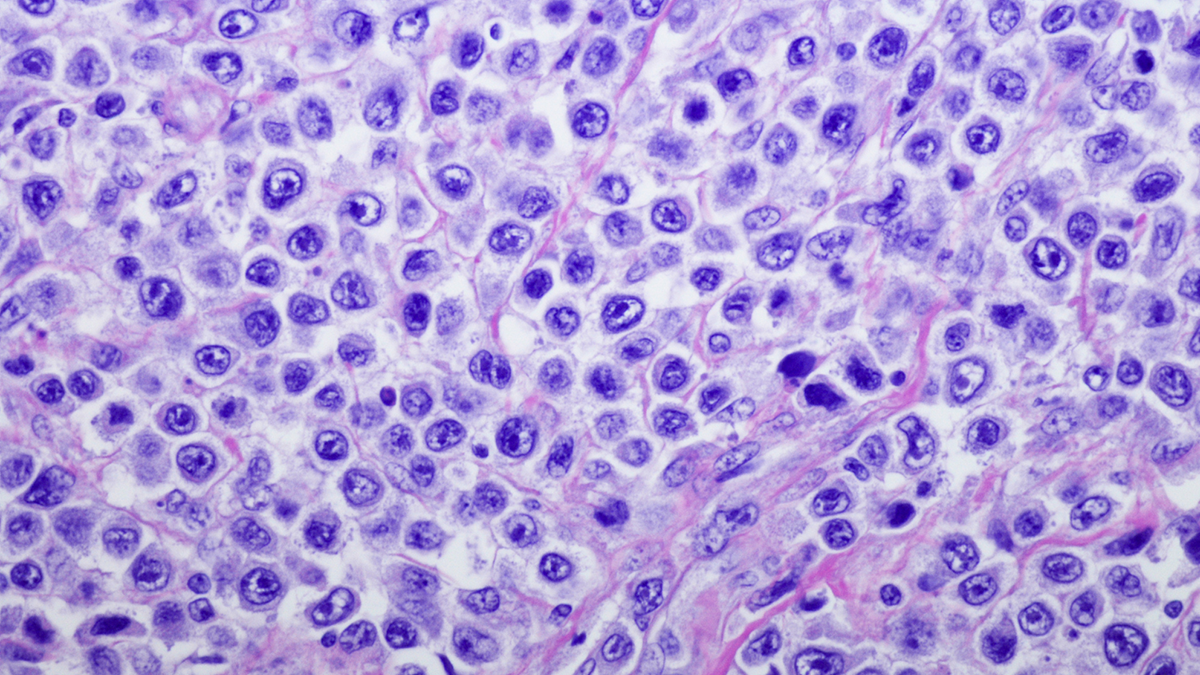
Glofitamab skuteczną terapią w nawrotowym chłoniaku rozlanym z dużych komórek B, także po terapii CAR-T

Chłoniak rozlany z dużych komórek B (ang. diffuse large B-cell lymphoma, DLBCL) to najczęstszy chłoniak u osób dorosłych: co roku w Polsce jest ok. 1,5 tys. przypadków nowych zachorowań. To choroba agresywna, szybko postępująca, która jednak u znacznej części pacjentów może być wyleczona już w pierwszej linii (standardem jest chemioimmunoterapia, do której u niektórych pacjentów dołącza się lek celowany – polatuzumab wedotyny, refundowany od stycznia 2024 r.). W ostatnich latach w Polsce widać znaczną poprawę dostępu do nowych leków immunologicznych w leczeniu postaci nawrotowych i opornych.
„Przełomem w postaciach nawrotowych i opornych chłoniaka jest zastosowanie nowoczesnej immunoterapii. Jest to technologia CAR-T, która obecnie jest w Polsce refundowana po drugiej linii, oraz przeciwciała bispecyficzne (dwuswoiste), które w Polsce na razie były dostępne jedynie w ramach badań klinicznych. Dostępność do nich powinna się poprawić, gdyż jest to leczenie wolne od chemioterapii, o udowodnionej skuteczności” – zaznacza prof. Krzysztof Giannopoulos, prezes Polskiego Towarzystwa Hematologów i Transfuzjologów.
Przeciwciało bispecyficzne o specyficznej budowie
Przeciwciała dwuswoiste (bispecyficzne) angażują limfocyty T chorego do niszczenia komórek chłoniaka. Jest to możliwe dzięki specyficznej budowie leku, który jednym swoim fragmentem łączy się z antygenem CD20 występującym na komórkach chłoniaka, a drugim łączy się z antygenem CD3 obecnym na limfocytach T. – „Przeciwciała dwuswoiste wykorzystują układ odpornościowy pacjenta, przyciągając komórkę chłoniakową do limfocytu cytotoksycznego, który ma na swojej powierzchni receptor CD3. Powoduje to rozpoznanie nieprawidłowych komórek i ich zniszczenie” – dodaje prof. Giannopoulos.
„Przeciwciała bispecyficzne to grupa leków, która zmieni krajobraz leczenia nowotworów układu chłonnego, zwłaszcza opornych i nawrotowych. Glofitamab jest przeciwciałem o dosyć specyficznej budowie cząsteczki. Jego konstrukcja jest bardzo ciekawa, ma on podwójne miejsce wiązania antygenu CD20, co zwiększa skuteczność leku” – tłumaczy prof. Tomasz Wróbel, kierownik Katedry i Kliniki Hematologii, Nowotworów Krwi i Transplantacji Szpiku, UM we Wrocławiu.
Lek został zarejestrowany w styczniu 2023 r. przez FDA, a w maju 2023 r. przez EMA w leczeniu pacjentów po dwóch i więcej liniach leczenia chłoniaka rozlanego z dużych komórek B. – „W badaniu, które stało się podstawą rejestracji leku brało udział 154 pacjentów, głównie z DLBCL, ale też z transformowanym chłoniakiem grudkowym oraz chłoniakiem śródpiersia. Pacjenci mieli za sobą od dwóch do siedmiu wcześniejszych linii leczenia. 60%. chorych otrzymało trzy i więcej terapii, a ok. 1/3 z nich to byli pacjenci, u których nastąpiła wznowa choroby po terapii CAR-T” – zaznacza prof. Wróbel.
Wyniki badania okazały się bardzo pozytywne. Punktem końcowym był odsetek całkowitych remisji. – „Przy czasie obserwacji 12,6 miesiąca ponad 50% pacjentów uzyskało odpowiedź na leczenie, a ok. 39%– całkowitą odpowiedź na leczenie. Cieszy fakt, że leczenie było skuteczne również u dużej części chorych, którzy wcześniej otrzymali terapię CAR-T” – zwraca uwagę prof. Wróbel. Ok. 30% pacjentów, u których doszło do nawrotu choroby po terapii CAR-T uzyskało całkowitą remisję po przyjmowaniu glofitamabu.
Istotne jest również to, że bardzo szybko było widać, którzy pacjenci reagują na leczenie i mogą z niego uzyskać korzyści: mediana czasu do uzyskania odpowiedzi wynosiła 42 dni, a w dodatku wydaje się, że u tych pacjentów, którzy uzyskali wcześnie korzyści z leczenia, mogą one być trwałe. – „W przypadku chorych, którzy uzyskali szybko odpowiedź na leczenie (po trzecim cyklu), mediana PFS (czas wolny od progresji choroby) wyniosła 31 miesięcy, a u 63% pacjentów wyniosła powyżej 24 miesięcy. Jeśli te wyniki utrzymają się to możemy się spodziewać, że u znacznego odsetka chorych uzyskamy długotrwałą kontrolę choroby” – zaznacza prof. Wróbel.
„To bardzo trudna grupa pacjentów, po wielu wcześniejszych liniach, w praktyce bez dobrych opcji terapeutycznych i źle rokująca. Z tego punktu widzenia efekty stosowania terapii są w zasadzie niespotykane” – podkreśla prof. Giannopoulos.
Lek „z półki” o ograniczonym czasie stosowania
Terapia CAR-T oraz przeciwciała bispecyficzne to dwa przełomy w leczeniu opornych i nawrotowych postaci DLBCL. Atutem przeciwciał bispecyficznych w stosunku do terapii CAR-T jest to, że są to leki gotowe, niemalże „z półki” – nie jest konieczne (jak w przypadku terapii CAR-T) długie oczekiwanie na przygotowanie leku, na co w przypadku pacjentów z opornym i nawrotowym chłoniakiem DLBCL często nie ma czasu. – „Przeciwciała bispecyficzne są produktami gotowymi do zastosowania już w momencie kwalifikacji do leczenia. Jest to pewna przewaga nad technologią CAR-T, choć nie powinniśmy tych terapii traktować jako technologie konkurujące, a raczej uzupełniające się” – zaznacza prof. Giannopulos.
Stosowanie glofitamabu może powodować ryzyko działań niepożądanych. Wiązały się one jednak z mniejszą toksycznością niż w przypadku CAR-T: w badaniu rejestracyjnym zdarzenia niepożądane prowadzące do przerwania leczenia odnotowano u 9% chorych (u 3% uznano je za związane z leczeniem), natomiast czasowe wstrzymanie lub modyfikacja dawkowania była konieczna u 19% chorych (u 10% uznano to za związane z leczeniem). Atutem stosowania glofitamabu jest też to, że jest to leczenie ograniczone w czasie. – „Stosuje się go maksymalnie przez 12 cykli terapii” – podkreśla prof. Wróbel.
Zdaniem ekspertów dostęp do przeciwciał bispecyficznych to obecnie jedna z największych niezaspokojonych potrzeb polskich pacjentów z opornym i nawrotowym DLBCL. – „Liczymy na to, że będziemy mogli stosować glofitamab u naszych pacjentów, ponieważ jest to forma leczenia wolna od chemioterapii, o sprawdzonych dowodach skuteczności, zarówno w grupie pacjentów wcześniej leczonych przeszczepieniem szpiku, jak i immunochemioterapią, a także również pacjentów, którzy nie mogą być zakwalifikowani do technologii CAR-T lub ją otrzymali, ale nastąpiła progresja choroby” – mówi prof. Giannopoulos. Glofitamab znalazł się na drugim miejscu na liście TOP 10 Hemato 2024, która powstała na podstawie wskazań ekspertów – członków zarządu Polskiego Towarzystwa Hematologów i Transfuzjologów.
„To lek, którego refundacja byłaby wskazana dla pacjentów z nawrotową i oporną postacią DLBCL, szczególnie że jest skuteczny także u pacjentów leczonych wcześniej terapią CAR-T, dla których obecnie właściwie nie mamy dobrej opcji terapii. Jest to niezwykle obiecująca terapia, wykorzystująca własny układ odpornościowy pacjenta” – podsumowuje prof. Wróbel.